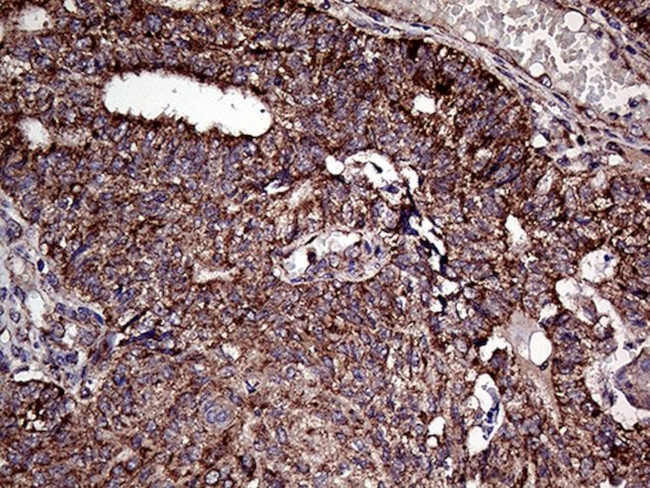
ATG4B Antibody in Immunohistochemistry (Paraffin) (IHC (P))

Search
OriGene
ATG4B Monoclonal Antibody (OTI1A3), TrueMAB™
{{$productOrderCtrl.translations['antibody.pdp.commerceCard.promotion.promotions']}}
{{$productOrderCtrl.translations['antibody.pdp.commerceCard.promotion.viewpromo']}}
{{$productOrderCtrl.translations['antibody.pdp.commerceCard.promotion.promocode']}}: {{promo.promoCode}} {{promo.promoTitle}} {{promo.promoDescription}}. {{$productOrderCtrl.translations['antibody.pdp.commerceCard.promotion.learnmore']}}
产品信息
CF810189
种属反应
宿主/亚型
分类
类型
克隆号
抗原
偶联物
形式
浓度
纯化类型
保存液
内含物
保存条件
运输条件
产品详细信息
For reconstitution, we recommend adding 100 µL distilled water to a final antibody concentration of about 1 mg/mL. To use this carrier-free antibody for conjugation experiments, we strongly recommend performing another round of desalting. (Zeba Spin Desalting Columns, 7KMWCO, 0.5 mL, Product # 89882)
靶标信息
Cysteine protease ATG4b is an enzyme which is coded by ATG4b gene. Autophagy is a critical cellular homeostatic process that controls the turnover of damaged organelles and protein. ATG4b is a deubiquitin-like protease that plays dual roles in the core machinery of autophagy. ATG4b, cleaves the C-terminal amino acid of ATG8 family proteins MAP1LC3, GABARAPL1, GABARAPL2 and GABARAP, to reveal a C-terminal glycine. Exposure of the glycine at the C-terminus is essential for ATG8 proteins conjugation to phosphatidylethanolamine (PE) and insertion to membranes, which is necessary for autophagy. ATG4b is mainly expressed in the skeletal muscle, brain, heart, liver and pancreas.
仅用于科研。不用于诊断过程。未经明确授权不得转售。
篇参考文献 (0)
生物信息学
蛋白别名: APG4 (ATG4) autophagy-related homolog B; APG4 autophagy 4 homolog B; ATG4 autophagy related 4 homolog B; AUT-like 1 cysteine; AUT-like 1 cysteine endopeptidase; AUT-like 1, cysteine endopeptidase; autophagin 1; Autophagin-1; autophagy related 4 homolog B; autophagy related 4B, cysteine peptidase; autophagy-related 4B; Autophagy-related cysteine endopeptidase 1; Autophagy-related protein 4 homolog B; Cysteine protease ATG4B; cysteine protease involved in autophagy APG4-B; hAPG4B; HsAPG4B; MmAPG4B
基因别名: 2510009N07Rik; APG4B; ATG4B; Atg4bl; AUTL1; AW048066; KIAA0943
UniProt ID: (Human) Q9Y4P1, (Mouse) Q8BGE6
Entrez Gene ID: (Human) 23192, (Mouse) 66615, (Rat) 316640